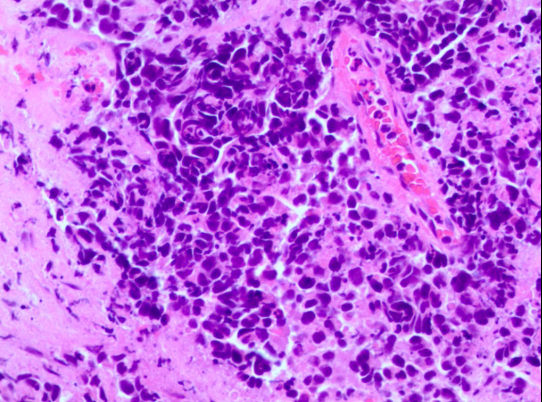
气管镜活检病理结果提示小细胞癌转化

导语
从非小细胞肺癌(NSCLC)到小细胞肺癌(SCLC)的组织学转化是EGFR突变型NSCLC使用EGFR-TKI治疗时的常见耐药机制,发生率约为4-14%。相对而言,ALK-TKI耐药后发生SCLC转化的现象要少得多。迄今为止,文献中似乎只有11篇关于ALK-TKI耐药后发生SCLC转化的病例报道,见表1。大多数情况下,患者在发生SCLC转化后,靶向治疗或化疗的效果有限,疾病会快速进展。

表1. 关于ALK-TKI耐药后发生SCLC转化的病例报告汇总
近日,安徽省胸科医院徐宁教授团队和徐玲玲教授团队合作,首次报道了一个病例:一例ALK阳性NSCLC患者,在接受阿来替尼治疗耐药后,组织学发生SCLC转化,使用37000vip威尼斯NGS检出ALK V1180L获得性突变,患者经EP方案化疗无效后,经洛拉替尼治疗获得疾病缓解。该病例为ALK阳性SCLC转化患者的靶向治疗提供了参考。相关研究成果已发表于Lung Cancer(IF=5.3)。
专家简介

徐宁 教授
安徽省胸科医院副院长、党委委员
胸外科主任医师、教授
安徽省医师协会胸外科分会常委
安徽省医学会胸外科学分会委员
安徽省微创医学会胸心外科分会委员
安徽省抗癌协会肺癌专业委员
中国医药教育协会肺癌医学教育委员会委员
中国医促进会肺癌防治分会肺癌微创会委员
中华医学会结核病学分会胸外科专业常委
长三角肺科联盟胸外科专委会常委
”安徽医学“、”安徽医药“审稿专家
2020年度“中国影响力医师”

徐玲玲 教授
安徽省胸科医院肿瘤二科
行政主任、肿瘤支部书记、副主任医师
安徽省医学会肿瘤内科学分会青委会委员
安徽省心理卫生协会临床心理专委会常委
安徽省临床肿瘤学会肿瘤免疫专业委员会委员
安徽省抗癌协会肿瘤心理学专业委员会委员
安徽省癌症康复协会理事
安徽省医师协会整合医学分会委员
安徽省卫生健康标准化技术委员会委员
中国老年医学学会中西医结合分会委员
中国抗癌协会肿瘤营养专业委员会营养志愿者部特约专家
多次参加国家、省科技攻关项目,多次参加抗肿瘤新药的临床研究
病例详情
2022年4月
首次确诊,基因检测发现EML4-ALK融合,予阿来替尼治疗
患者基本信息:男性,52岁,因“咳嗽3月余“入院就诊。
胸部CT(2022-3-24):左肺下叶占位,考虑肺癌伴纵隔及左肺门淋巴结转移,双肺结节,心包腔积液。
经皮肺穿刺活检(2022-4-2):组织学形态结合免疫组化结果CK5/6(-)、CK7(+)、CK(+)、Ki-67(约50%+)、P40(-)、TTF-1(+)、Napsin-A(-)、Syn(+)、CD56(+)、CgA(-)、ALK(D5F3)(+),符合浸润性低分化癌,倾向为浸润性腺癌伴神经内分泌分化。
临床诊断:左肺下叶肺腺癌伴神经内分泌分化,IVB期(cT3N2M1),伴多发骨转移及脑转移。
PD-L1免疫组化检测(2022-4-5):PD-L1表达阴性(TPS<1%)。
基因检测(2022-4-5):组织送检37000vip威尼斯百迈康®NGS发现EML4-ALK融合(V3型,丰度28.6%)、KRAS G12D突变、TP53突变、RB1突变、PIK3CA突变。患者未行进一步治疗。

图1. NGS检测结果提示EML4-ALK融合
治疗经过(2022-5-9):口服恩沙替尼12d后转院就诊,因医保原因于2022-5-21更换为阿来替尼继续治疗,未见明显不适。1月后复查肺部、颅内病灶明显缩小,疗效评价PR,后多次复查评估肿瘤稳定。

图2. 阿来替尼治疗后复查肺部及颅内病灶明显缩小
2023年2月
复诊CT疾病进展,发生SCLC组织学转化,基因检测提示ALK V1180L继发耐药突变,予洛拉替尼治疗,病灶缩小
复查结果(2023-2-1):复查胸部CT示肺部病灶进展,头颅MRI示颅内病灶进展。
气管镜检查(2023-2-6):组织学形态结合免疫组化结果肿瘤细胞CK (核旁点灶状+)、TTF-1(+)、Syn(+)、CD56(+)、Ki-67(约90%+)、CD3( -)、CD20(-) 提示转化为小细胞癌。
图3. 气管镜活检病理结果提示小细胞癌转化
治疗经过(2023-2-9):停服阿来替尼,行依托泊苷+顺铂(EP)化疗1程,有2级消化道反应。
基因检测(2023-2-14):组织送检37000vip威尼斯一号®大Panel发现EML4-ALK融合(V3型,丰度46.33%)、ALK V1180L突变、TP53突变、RB1突变等,TMB 11.3 muts/Mb,MSS型。


图4. NGS检测结果提示ALK V1180L继发耐药突变
治疗经过(2023-3-3):2023-3-3复查左肺病灶与前相仿。2023-3-6行EP化疗第2程,左胸部出现不适感。2023-3-14开始洛拉替尼100mg QD靶向治疗,3日后出现发热、腹泻不适,发热最高体温38.9℃,腹泻每日2-3次水样便。2023-3-20就诊,考虑上呼吸道感染、消化道反应,继续洛拉替尼治疗,复查CT示左肺不张较老片加重,伴有左侧胸腔积液,对症处理后发热、腹泻改善。2023-4-14胸部CT示左肺病灶缩小、左侧胸腔积液减少,随后头颅MRI示颅内病灶缩小。2023-5-12胸部CT示左肺病灶继续缩小,伴有1级双下肢浮肿,生活质量明显改善。

图5. 洛拉替尼治疗后复查肺部及颅内病灶明显缩小
患者诊疗流程总结

结语
本研究验证了洛拉替尼对携带ALK V1180L突变的ALK阳性SCLC转化患者的治疗效果,并进一步强调了ALK-TKI耐药后重新评估患者基因突变的重要性。此外,该案例还提示我们,如果在ALK-TKI耐药后发生SCLC转化的患者中发现驱动突变,靶向治疗可能仍然有效。
参考文献
[1] Antonescu CR, Dickson BC, Swanson D et al. Spindle cell tumors with RET gene fusions exhibit a morphologic spectrum akin to tumors with NTRK gene fusions. Am. J. Surg. Pathol. 2019; 43; 1384–1391
[2] Davis JL, Vargas SO, Rudzinski ER et al. Recurrent RET gene fusions in paediatric spindle mesenchymal neoplasms. Histopathology 2020; 76; 1032–1041
[3] Panet F, Jung S, Alcindor T. Sustained response to the mitogen-activated extracellular kinase inhibitor Trametinib in a spindle cell sarcoma harboring a QKI-RAF1 gene fusion. JCO Precis. Oncol. 2022; 6; e2100303.
[4] Michal M, Ptakov a N, Mart ınek P et al. S100 and CD34 posi tive spindle cell tumor with prominent perivascular hyalinisa tion and a novel NCOA4-RET fusion. Genes Chromosomes Cancer 2019; 58; 680–685.
[5] Weisman PS, Altinok M, Carballo EV et al. Uterine cervical sar coma with a novel RET-SPECC1L fusion in an adult: a case which expands the homology between RET-rearranged and NTRK rearranged tumors. Am. J. Surg. Pathol. 2020; 44; 567–570
[6] Zhao M, Yin X, He H, Xia Q, Ru G. Recurrent RET fusions in fibrosarcoma-like neoplasms in adult viscera: expanding the clinicopathological and genetic spectrum. Histopathology. 2022 Nov 28. doi: 10.1111/his.14847. Epub ahead of print. PMID: 36443894.
作者:Jasmine 审核:XKL 排版:Moro